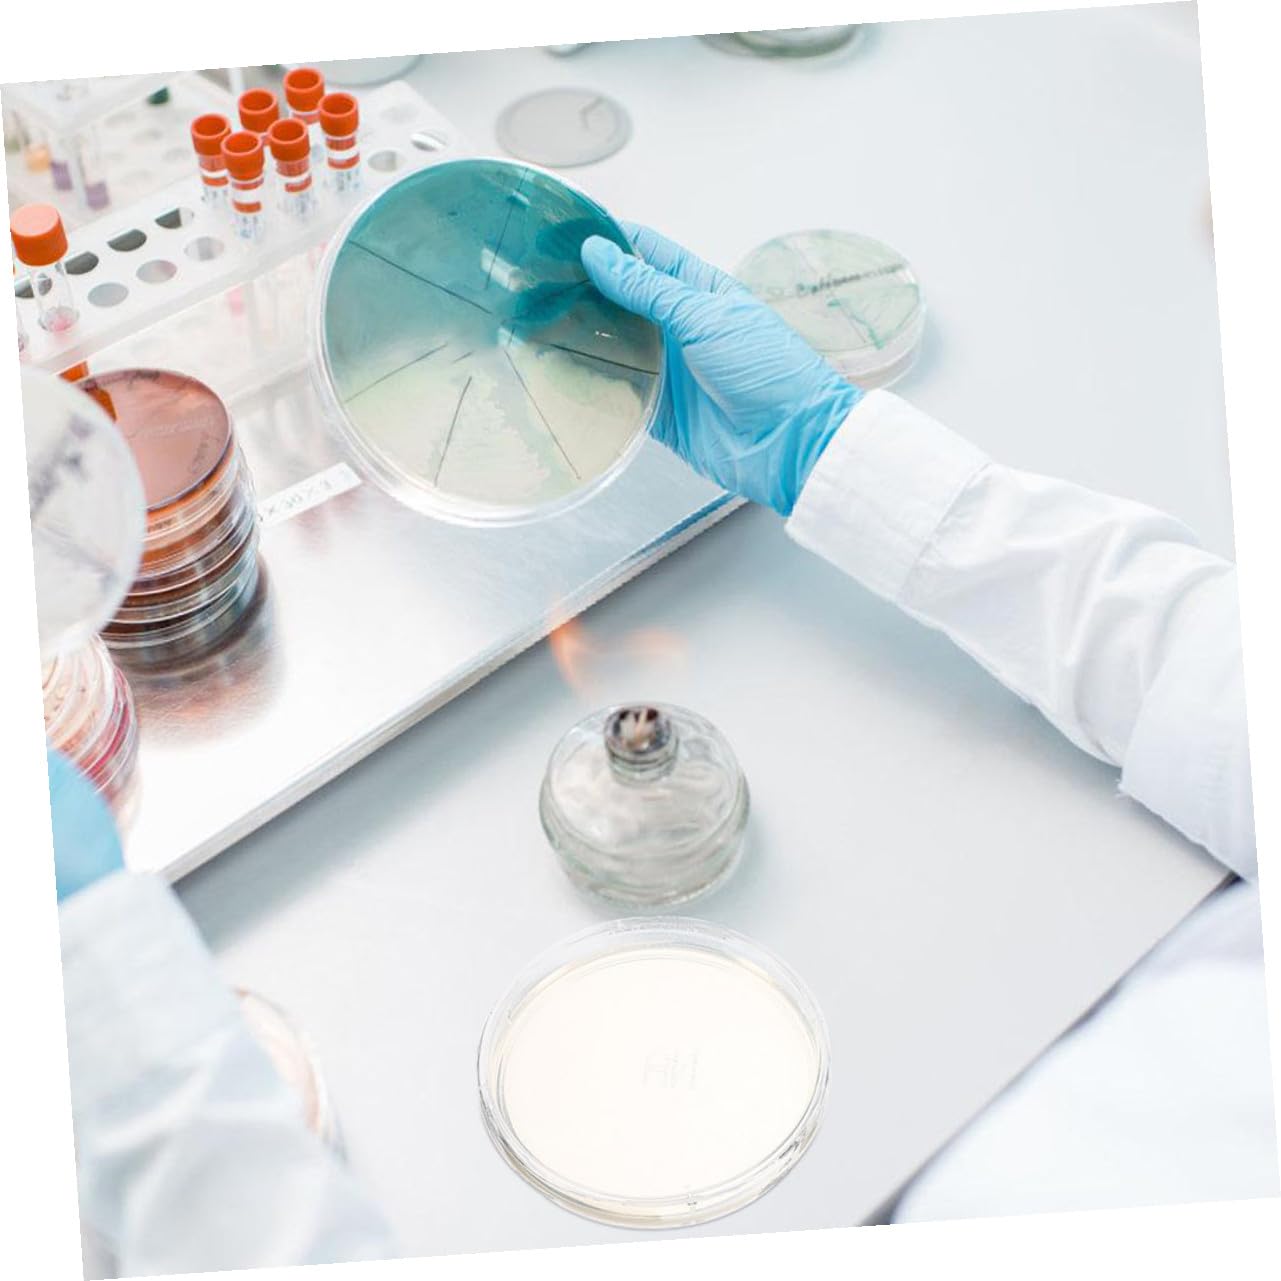

SAFIGLE 10pcs Nutrient Agar Petri Dishes 6cm with Lid for Microbiology Experiments Laboratory Cell Culture Plates Science Experiment Supplies
 Limited Time Sale
Limited Time Sale$54.00 cheaper than the new price!!
Free cash-on-delivery fees for purchases over $99
Product details
| Management number | 211014070 | Release Date | 2026/04/04 | List Price | $36.00 | Model Number | 211014070 | ||
|---|---|---|---|---|---|---|---|---|---|
| Category | |||||||||
Package List 10 x Nutritional Agar Plates Features -Size:6.00X6.00X2.00cm/2.36X2.36X0.79in -Durable quality: manufactured from durable materials to with the product's stability and reliability, delivering consistent experimental results -Nutrient-packed: loaded with essential nutrients ensuring optimal conditions for various scientific experiments transparent petri dishes -Color:Multi -Trustworthy: subjected to strict quality control and testing to ensure the product's accuracy and dependability, making it a reliable tool for your experimental needs lab themed parties -Easy to use design: the plate shape is convenient for handling and use, making it suitable for a variety of laboratory tasks and research projects specimen dishes -Material:Agar -Multifunctional: for cultivation, screening, and laboratory research, providing versatility for different scientific applications petri agar plates -Product Info: Nutrient agar platesGoods Informationresearch petri dishes Their design and nutrient-rich medium ensure reliable performance in any laboratory or educational setting.scientific plates These microbiology plates meet the needs of researchers, educators, and hobbyists by providing a dependable platform for culture.petri plate specimen From science experiments to industrial testing, they support a variety of applications
- Durable quality: crafted from durable materials to with the stability and dependability of the product, ensuring accurate experimental results,petri agar plates,lab petri dishes
- Durable: made from durable materials to ensure stable and reliable product quality, providing consistent results in your experiments,petri plate specimen,lab petri dish
- Ease of use: the plate design is practical and easy to use, making it ideal for both professional and educational laboratory environments,cell culture dishes,industrial application plates
- Easy to use design: the plate shape is convenient for handling and use, making it suitable for a variety of laboratory tasks and research projects,school science projects,culture dish
- Easy to use: the plate design is convenient for handling and use, making it an for both professional and educational laboratory environments,specimen storage dishes,plates for laboratory use
| Item Weight | 10.6 ounces |
|---|---|
| Manufacturer | SAFIGLE |
| Item model number | 1UU1124814V0X |
| Product Dimensions | 2.36 x 2.36 x 0.79 inches |
Correction of product information
If you notice any omissions or errors in the product information on this page, please use the correction request form below.
Correction Request Form